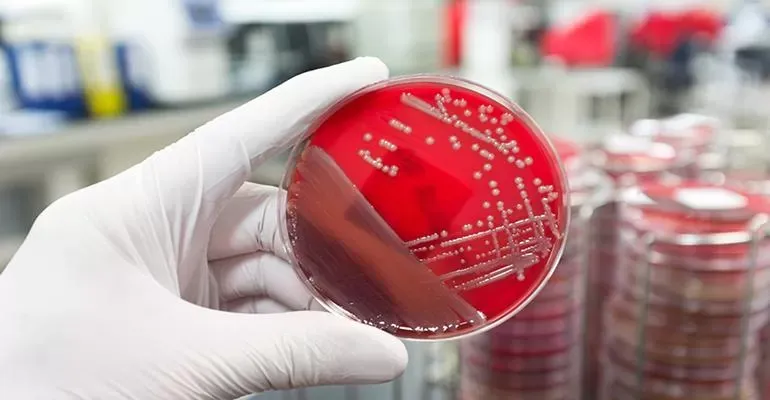
Antimicrobial-Resistance.jpg Antimicrobial-Resistance.jpg

Medical Laboratory
More Topics
Current Topics and Challenges in Antimicrobial ResistanceCurrent Topics and Challenges in Antimicrobial Resistance
This webinar highlights the current challenges in today’s microbiology laboratory.
Subscribe to WHX Insights newsletter
Stay at the forefront of healthcare trends & innovations
.webp?width=1280&auto=webp&quality=80&disable=upscale)









.png?width=300&auto=webp&quality=80&disable=upscale)























